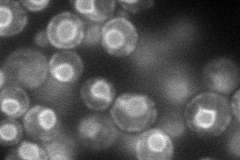
YLR088W
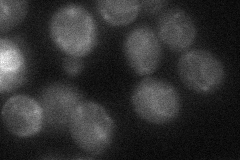
YLR088W
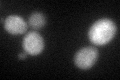
YLR088W

View description
Subunit of the GPI (glycosylphosphatidylinositol):protein transamidase complex, removes the GPI-anchoring signal and attaches GPI to proteins in the ER
Localization:
Intensity:
Fold change:
Significance:
-
C’ GFP library in SD

ER23.07 -
N' NOP1pr-GFP in SD
ER78.7233 -
N' TEF2pr-mCherry in SD

ER,punctate124.667 -
N' NATIVEpr-GFP in SD

ER25.4217 -
N' TEF2pr-VC and Cyto-VN in SD
ER33.3662 -
C’ GFP library in SD+DTT
ER22.360.96No -
C’ GFP library in SD+H2O2

ER22.370.96No -
C’ GFP library in Starvation Media

ER22.640.98No -
C’ GFP library on the background of Pup2-DaMP

ER -
C’ GFP library on the background of CCT mutant

ER18.89230.818867No
